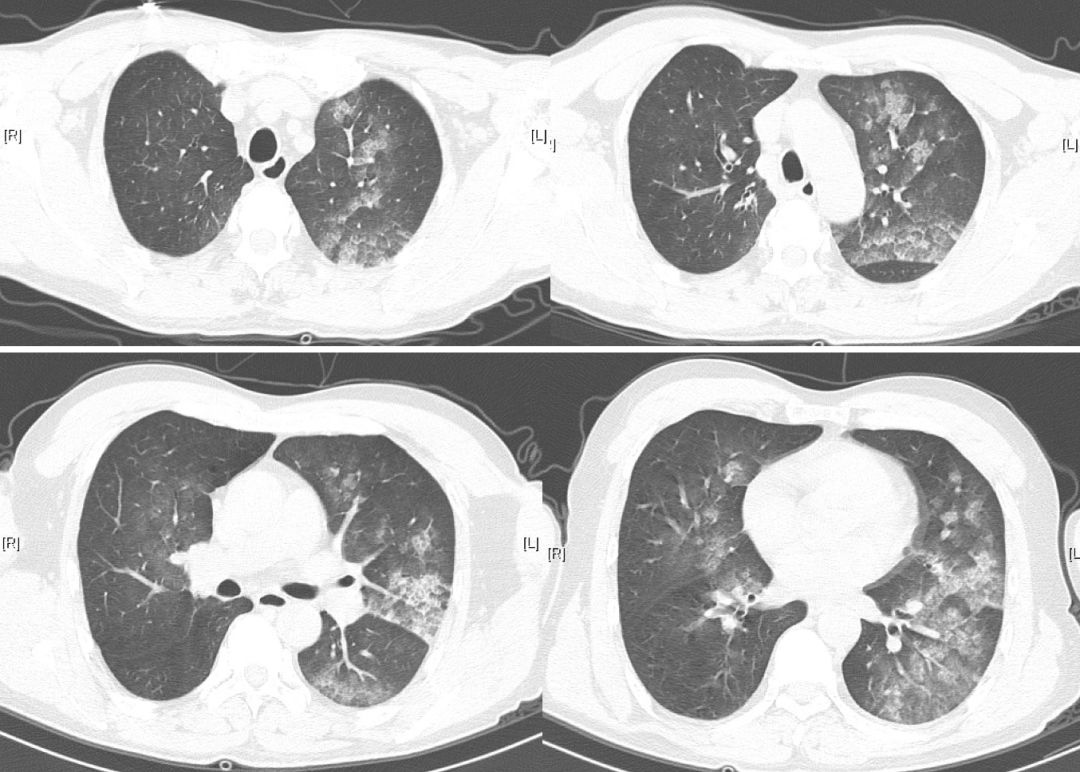
工人用稀料清理泡沫10分钟即意识丧失，肝功能异常是否为切入点？

推荐语
对于呼吸医生来说,临床可能遇到吸入化学刺激物,出现急性中毒的病人。由于病人缺乏防护意识、自身不重视,患者起病急、入院时病情重,处理起来相当棘手。
遇到这种病人,临床上如何进行呼吸支持、控制全身和肺脏的炎症反应、纠正休克、纠正酸中毒、改善凝血功能,提高患者存活率?吸入化学刺激物后期可造成支气管扩张、闭塞性支气管炎、肺纤维化,导致肺功能低下,临床如何处理和改善?
为此,《呼吸界》已推出「吸入之殇」系列,和大家分享在处理吸入性呼吸重症病人时的亲身经历和宝贵经验。
三位工人第一天从事此项工作就都出现不同程度中毒?
用稀料清理泡沫后意识丧失,清醒后又呼吸困难
患者于2016年3月15日上午与工友一起在室外从事墙壁残余泡沫清理工作,该场所曾用于展览用途,工作中需要使用稀料清理泡沫,工作场所宽1米,长8米,高4米,通风欠佳,有刺激性气味,患者工友于高处工作,气味较小,底部气味较大,患者在进入工作场所底部作业,使用稀料100 ml,约10分钟后出现意识丧失,10分钟后被两名工友救出。患者约2分钟后意识转清,有头晕、咳嗽、咳痰、呼吸困难症状。施救患者的两名工友也同时感不适就医。3名患者均为第一天从事此项工作,无口罩、手套等防护措施,未接受过培训。其工作所用稀料在我院毒物化学实验室检测,成分为三氯甲烷。
他们的临床资料有何异同?异常的肝功能提示了啥?
病例1(底部作业工人)
患者男性,47岁。接触三氯甲烷后出现意识丧失,意识转清后患者有头晕、咳嗽、咳痰、呼吸困难症状。查体:T 36.5℃,P 64次/分,RR 20次/分,BP 123/70 mmHg。神清,精神弱,口唇发绀,巩膜无黄染,双肺可闻及湿罗音,心率98次/分,律齐,心音有力,未闻及心脏杂音,腹软,无压痛,肝脾肋下未触及,双下肢无水肿,四肢肌力,肌张力正常,无震颤,膝反射、跟腱反射存在,病理征阴性。既往体健。吸烟30年,6支/天,未戒烟。
呼吸室内空气时,动脉血气分析示PH 7.38,PaCO2 43 mmHg,PaO2 61 mmHg,HCO3- 23 mmol/L,SaO2 90%。血常规:白细胞 3.49×10^9/L,中性粒细胞 79.6%,血红蛋白 138 g/L,血小板 139×10^9/L。肝功能明显异常【表1】;尿常规和生化肾功能正常,凝血检查正常,乙肝表面抗原和丙肝抗体均阴性。头颅CT未见脑水肿。腹部超声肝胆未见异常。心电图为窦性心律,大致正常。心脏彩超示心脏结构和功能未见明显异常。发病当日胸片示双肺呈向心性分布的磨玻璃影。

【表1】急性三氯甲烷中毒患者肝功能指标的变化
注:NA:未做此项检查
缩略语:AST= 谷草转氨酶,ALT = 谷丙转氨酶,TBIL = 总胆红素,DBIL=直接胆红素,IBIL = 间接胆红素,CREA = 肌酐
胸部CT:双肺沿支气管血管束分布肺泡填空影,提示肺泡性肺水肿【图1-2】。支气管镜镜下见支气管粘膜明显充血【图3A】。左下肺叶支气管开口粘膜活检病理:组织被覆上皮部分脱落,基底膜增厚,间质性水肿,散在及灶状淋巴细胞浸润【图3B】。

【图1】后前位X线胸片
(A)病例1患者接触三氯甲烷当日胸片,双肺向心性分布的渗出阴影,左肺为著;(B)第4天胸片,双肺渗出影较前明显吸收好转。
【图2】接触三氯甲烷当天胸部HRCT
双肺多发斑片状渗出灶,呈向心分布,左肺为著,符合肺水肿。

【图3】接触三氯甲烷第4天
(A)支气管镜下可见支气管粘膜广泛充血。(B)支气管粘膜活检,低倍镜下见组织被覆上皮部分脱落(箭头),基底膜增厚,间质性水肿,散在及灶状淋巴细胞浸润
入院后给予患者心电监护,先给予文丘里面罩吸氧,氧浓度35%,病情好转后改为鼻导管吸氧。静脉甲强龙 80 mg QD × 4d,40 mg QD ×4d,之后改为口服甲强龙 24 mg QD × 7d,逐渐减量至停药。口服利尿剂、雾化布地奈德,每次2mg,BID。保肝治疗给予还原性谷胱甘肽1.2 g QD ivgtt × 7d。
病例2、3(救患者的两位工友)
男性,年龄分别25岁和38岁,均出现头晕、咽干,无呼吸困难、无恶心、呕吐。2例患者均未出现低氧血症,胸片未见明显异常。生化肝功异常,谷草转氨酶、谷丙转氨酶、总胆红素、直接胆红素和间接胆红素均轻度增高。尿常规和生化肾功能正常。在急诊处置,给予保肝、对症支持治疗,观察3d,肝功能指标复查无异常后离院。
谈谈「麻醉神经,损伤器官」的幕后黑手
三氯甲烷(trichloromethane,chloroform,CHCL3)又名氯仿,为无色、易挥发的液体,有特殊的甜味 [1]。三氯甲烷曾主要用作麻醉剂,目前用作脂类、橡胶、油漆、磷的溶剂和萃取剂,在制造合成纤维、塑料、杀虫剂、干洗剂的过程中均可接触 [1,2] ,目前在工业上作为溶剂用途广泛 [1,4],在职业环境中主要是通过呼吸道和皮肤接触吸收 [3],如果防护不当,容易导致三氯甲烷中毒。
三氯甲烷中毒的主要靶器官为中枢神经系统、肝脏和肾脏,*气光**的主要靶器官为呼吸系统。
本文病例1在接触溶剂三氯甲烷后出现意识不清,肝功能损害,肺水肿;病例2和病例3亦出现神经系统、肝功能损害,结合患者接触史,临床资料和实验室结果,参照职业性急性化学物中毒的诊断总则和职业性急性*气光**中毒诊断标准 [5,6],病例1诊断为急性中度三氯甲烷中毒和急性重度*气光**中毒,病例2和病例3诊断为急性轻度三氯甲烷中毒。
近年来,陆续有三氯甲烷中毒的报道,主要损伤器官为肝脏 [7-9],在我们的报道中中毒途径为吸入,损伤器官为肝脏和肺脏;三氯甲烷遇光时与空气中的氧分子作用,分解生成*气光**和氯化氢,*气光**吸入导致肺损伤。
三氯甲烷可以通过消化道、呼吸道和皮肤接触进入机体,经消化道吸收快而完全,以蒸汽形式经呼吸道吸入时,人体吸收率为66%左右,双手浸入三氯甲烷液体1分钟,相当于吸入11.8g/m³浓度三氯甲烷1分钟 [1]。
本文中患者中毒方式为呼吸道吸入和皮肤接触。三氯甲烷进入机体后,迅速分布于全身各组织,在脂肪、大脑、肝脏和肾脏的含量相对较高。三氯甲烷属中等毒性,主要作用于中枢神经系统,具有麻醉作用,并具有肝肾毒性。三氯甲烷在体内的中间代谢产物*气光**,导致谷胱甘肽耗竭和脂质过氧化,引起肝脏、肾*毒脏**性作用 [1,10]。
本文中病例1出现意识不清和肝功能损害,与三氯甲烷中毒的靶器官一致,患者没有出现肾脏功能不全。入院后给予还原性谷胱甘肽保肝治疗,患者转氨酶逐渐下降,病情恢复。对于急性重度三氯甲烷中毒合并急性肝衰竭者,可以应用血液灌流术联合血浆置换术 [9],并且血浆置换术对免疫系统功能具有调节作用 [11]。
三氯甲烷遇光分解生成*气光**,*气光**又称碳酰氯,常温下是无色、有霉变干草和腐烂水果样气味的气体,高浓度时有辛辣味,*气光**毒性比氯气约大10倍,属高毒类,主要毒性是呼吸系统损害,可导致肺化学性炎症和肺水肿。*气光**中毒的机制是*气光**的羟基与肺组织细胞内的蛋白质、酶及类脂的功能基团结合发生酰化反应,干扰细胞正常代谢,使细胞膜和肺泡Ⅱ型上皮细胞破坏,表面活性物质生成减少,导致肺泡萎陷,肺顺应性降低,临床表现为化学性肺炎和肺水肿 [1]。本例较重患者的治疗过程表明,对于化学性肺水肿急性期的治疗,立即给予全身激素,静脉甲泼尼龙初始剂量为每天1 mg/kg,治疗反应好,激素不宜过早停用,否则可能出现化学性肺水肿复发,应逐步减药至停用。
此次事件导致3名工人急性三氯甲烷中毒,其中1例病情较重,经过治疗,患者病情均得到缓解,预后较好。三氯甲烷中毒没有特效解毒剂,采取综合治疗。中毒救治时需要考虑到三氯甲烷产生*气光**的肺毒性作用,对于其导致的肺水肿治疗,早期足量足疗程应用激素是急性期治疗的关键。在接触有毒化学物质前,岗前教育和做好防护措施是避免发生急性中毒的关键。
参考文献
[1] 何凤生.中华职业医学[M].北京:人民卫生出版社,2002:492-493.
[2] Sridhar N, Krishnakishore C,Sandeep Y, et al. Chloroform poisoning-a case report[J]. Renal Failure,2011,33(10):1037-1039.
[3] 姚峰,冯玉妹,张雪涛.急性三氯甲烷中毒一例报告[J].环境与职业医学,2012,2(5):324-325.
[4] Lionte C. Lethal complications after poisoning with chloroform–Case report and literature review[J]. Hum Exp Toxicol,2010,29(7):615–622.
[5] 中华人民共和国卫生部.GBZ 71—2013 职业性急性化学物中毒的诊断(总则)[S]. 北京:中国标准出版社,2013.
[6] 中华人民共和国卫生部.GBZ 29—2011 职业性急性*气光**中毒诊断标准[S]. 北京:中国标准出版社,2011.
[7] 罗进斌,林惠芬,黄方取,等.一起急性三氯甲烷中毒事故的调查[J].环境与职业医学,2014,31(6):462-466.
[8] 谢伟群,康美香,熊俊,等.1起职业性急性三氯甲烷中毒事故调查[J].中国职业医学,2014,41(1):119-120.
[9] 夏丽华,邓小峰,张莹,等.血浆置换联合血液灌流抢救急性重度三氯甲烷中毒[J].中国职业医学,2013,40(4):309-310.
[10]el-Shenawy NS1, Abdel-Rahman MS.The mechanism of chloroform toxicity in isolated rat hepatocytes[J].Toxicol Lett, 1993, 69(1):77-85.
[11] Gong D, Ji D, Xu B, et al.More selective removal of myeloperoxidase-anti-
neutrophil cytoplasmic antibody from the circulation of patients with vasculitides using a novel double-filtration plasmapheresis therapy[J]. Ther Apher Dial, 2013, 17(1):93-98.
作者介绍

叶俏,主任医师、教授、博士生导师;北京朝阳医院职业病与中毒医学科主任;中华医学会呼吸分会间质病肺疾病学组委员;中国医师协会间质性肺疾病工作组委员;中华预防医学会职业病分会委员 等。

牛颖梅,博士,副主任医师,首都医科大学附属北京朝阳医院职业病与中毒医学科,从事职业病、急慢性化学品中毒诊治工作。以第一作者发表SCI论文4篇,在国内核心期刊发表学术论文20篇。
国家科技重大专项重大新药创制(编号2014ZX09J15104),抗毒药物与毒理学国家重点实验室开放课题(TMC201503),北京市卫生系统高层次卫生技术人才项目(2015-3-024)